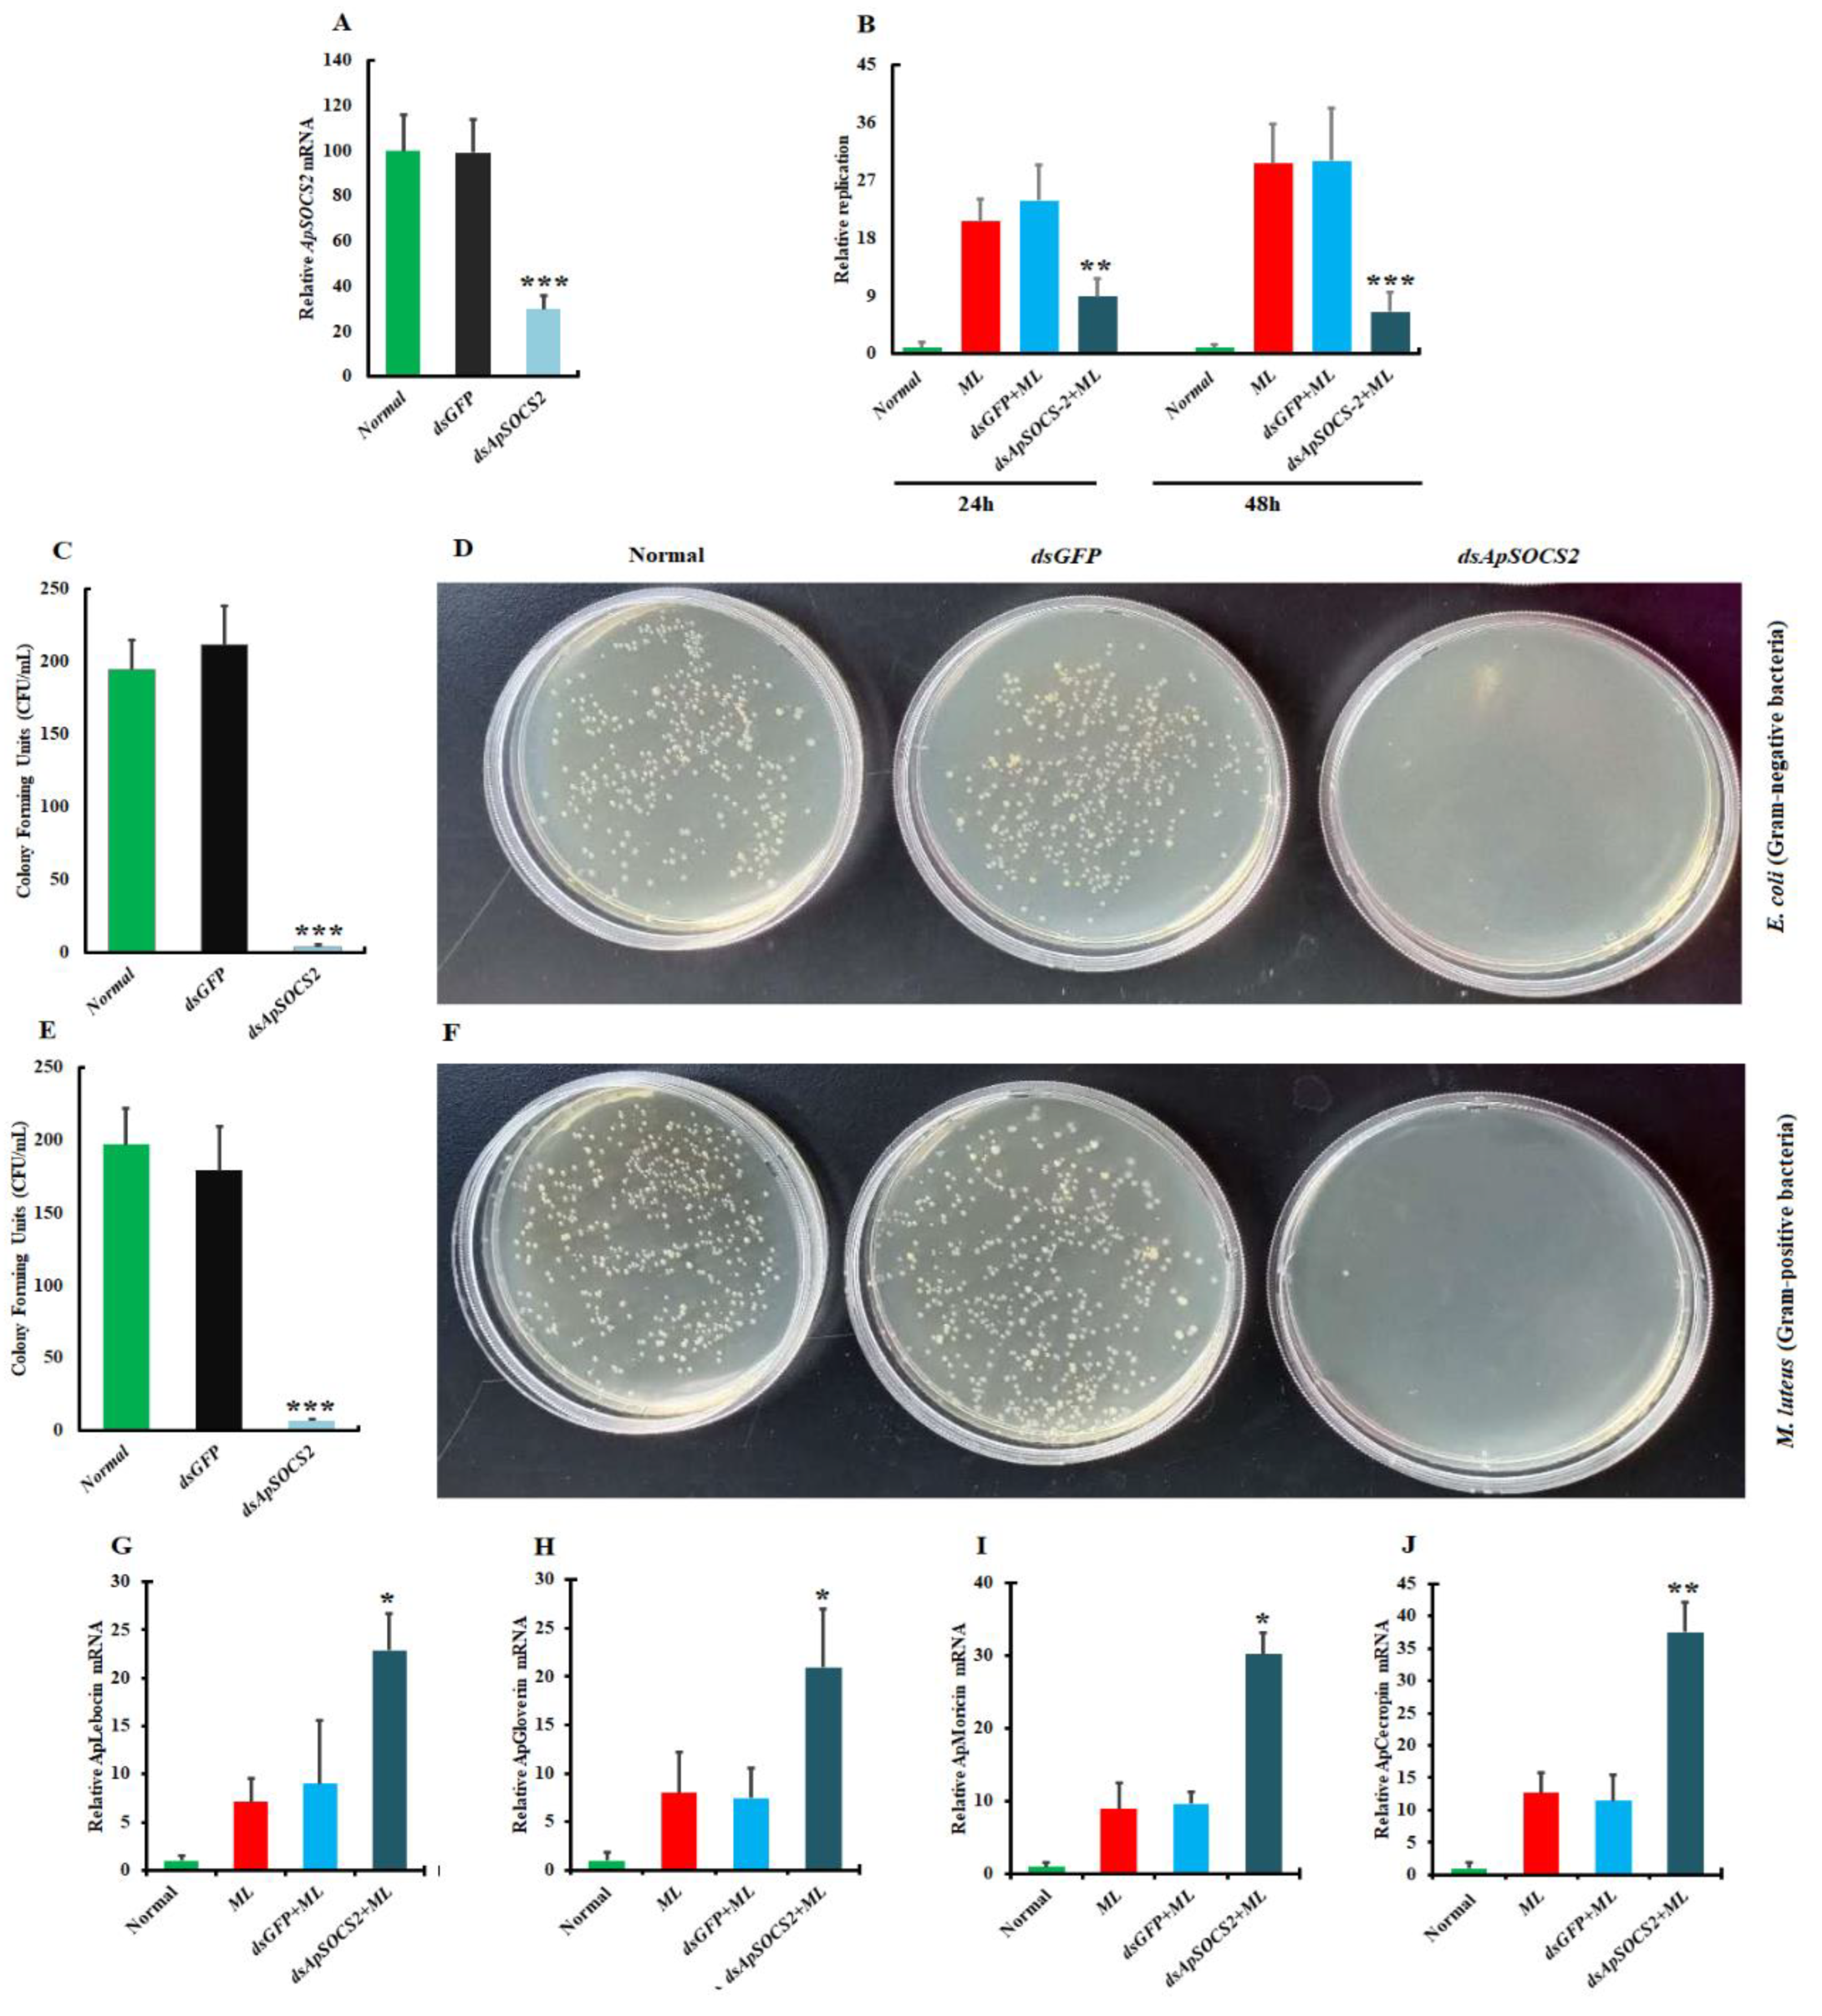
Ijms 23 10389 g007 550

Antheraea pernyi Suppressor of Cytokine Signaling 2 Negatively Modulates the JAK/STAT Pathway to Attenuate Microbial Infection
Abstract
:1. Introduction
2. Results
2.1. Sequence and Phylogenetic Analysis of ApSOCS-2
2.2. Protein Expression and Western Blot Analysis
2.3. Spatial Expression of ApSOCS-2 Transcripts
2.4. Microbial Challenge-Induced Expression of ApSOCS-2 Transcripts
2.5. ApSOCS-2 In Vivo Knockdown Reduced Bacterial Replication
2.6. Effect of ApSOCS-2 Knockdown on Bacterial Clearance
2.7. ApSOCS-2 Regulates the Production of AMPs
2.8. ApStat Modulates ApSOCS-2 Production in A. pernyi Challenged with M. luteus
2.9. Effects of ApSOCS-2 Suppression on the Gene Expression Patterns of A. pernyi
3. Discussion
4. Materials and Methods
4.1. Experimental Animals
4.2. Identification and Bioinformatics Analysis of ApSOCS-2
4.3. Recombinant Protein Expression and Purification
4.4. Tissue Distribution Analysis and Immune Challenge Studies
4.5. ApSOCS-2 Gene Silencing
4.6. Effect of ApSOCS-2 Depletion or Recombinant Protein Administration on AMP Gene Expression
4.7. Antibacterial Activity of Plasma
4.8. DNA Isolation and qPCR
4.9. Effect of ApStat Knockdown on ApSOCS-2 Expression
4.10. Transcriptome Analysis
4.11. Statistical Analysis
5. Conclusions
Supplementary Materials
Author Contributions
Funding
Institutional Review Board Statement
Informed Consent Statement
Data Availability Statement
Acknowledgments
Conflicts of Interest
References
- Kimbrell, D.A.; Beutler, B. The evolution and genetics of innate immunity. Nat. Rev. Genet. 2001, 2, 256–267. [Google Scholar] [CrossRef] [PubMed]
- Hetru, C.; Troxler, L.; Hoffmann, J.A. Drosophila melanogaster antimicrobial defense. J. Infect. Dis. 2003, 187 (Suppl. S2), S327–S334. [Google Scholar] [CrossRef] [PubMed]
- Tauszig, S.; Jouanguy, E.; Hoffmann, J.A.; Imler, J.L. Toll-related receptors and the control of antimicrobial peptide expression in Drosophila. Proc. Natl. Acad. Sci. USA 2000, 97, 10520–10525. [Google Scholar] [CrossRef]
- Kausar, S.; Abbas, M.N.; Gul, I.; Liu, R.; Li, Q.; Zhao, E.; Lv, M.; Cui, H. Molecular Identification of Two DNA Methyltransferase Genes and Their Functional Characterization in the Anti-Bacterial Immunity of Antheraea pernyi. Front. Immunol. 2022, 13, 855888. [Google Scholar] [CrossRef]
- Lemaitre, B.; Hoffmann, J. The host defense of Drosophila melanogaster. Annu. Rev. Immunol. 2007, 25, 697–743. [Google Scholar] [CrossRef]
- Naitza, S.; Ligoxygakis, P. Antimicrobial defences in Drosophila: The story so far. Mol. Immunol. 2004, 40, 887–896. [Google Scholar] [CrossRef]
- Kausar, S.; Abbas, M.N.; Gul, I.; Liu, Y.; Tang, B.-P.; Maqsood, I.; Liu, Q.-N.; Dai, L.-S. Integrins in the Immunity of Insects: A Review. Front. Immunol. 2022, 13, 906294. [Google Scholar] [CrossRef]
- Liu, Q.; Kausar, S.; Tang, Y.; Huang, W.; Tang, B.; Abbas, M.N.; Dai, L. The Emerging Role of STING in Insect Innate Immune Responses and Pathogen Evasion Strategies. Front. Immunol. 2022, 13, 874605. [Google Scholar] [CrossRef]
- Lotem, J.; Sachs, L. Cytokine control of developmental programs in normal hematopoiesis and leukemia. Oncogene 2002, 21, 3284–3294. [Google Scholar] [CrossRef]
- Seif, F.; Khoshmirsafa, M.; Aazami, H.; Mohsenzadegan, M.; Sedighi, G.; Bahar, M. The role of JAK-STAT signaling pathway and its regulators in the fate of T helper cells. Cell Commun. Signal. CCS 2017, 15, 23. [Google Scholar] [CrossRef] [Green Version]
- Abbas, M.N.; Kausar, S.; Zhao, E.; Cui, H. Suppressors of cytokine signaling proteins as modulators of development and innate immunity of insects. Dev. Comp. Immunol. 2020, 104, 103561. [Google Scholar] [CrossRef]
- Inagaki-Ohara, K.; Kondo, T.; Ito, M.; Yoshimura, A. SOCS, inflammation, and cancer. JAK-STAT 2013, 2, e24053. [Google Scholar] [CrossRef]
- Kile, B.T.; Schulman, B.A.; Alexander, W.S.; Nicola, N.A.; Martin, H.M.E.; Hilton, D.J. The SOCS box: A tale of destruction and degradation. Trends Biochem. Sci. 2002, 27, 235–241. [Google Scholar] [CrossRef]
- Kamura, T.; Maenaka, K.; Kotoshiba, S.; Matsumoto, M.; Kohda, D.; Conaway, R.C.; Conaway, J.W.; Nakayama, K.I. VHL-box and SOCS-box domains determine binding specificity for Cul2-Rbx1 and Cul5-Rbx2 modules of ubiquitin ligases. Genes Dev. 2004, 18, 3055–3065. [Google Scholar] [CrossRef]
- Hilton, D.J.; Richardson, R.T.; Alexander, W.S.; Viney, E.M.; Willson, T.A.; Sprigg, N.S.; Starr, R.; Nicholson, S.E.; Metcalf, D.; Nicola, N.A. Twenty proteins containing a C-terminal SOCS box form five structural classes. Proc. Natl. Acad. Sci. USA 1998, 95, 114–119. [Google Scholar] [CrossRef]
- Tannahill, G.M.; Elliott, J.; Barry, A.C.; Hibbert, L.; Cacalano, N.A.; Johnston, J.A. SOCS2 can enhance interleukin-2 (IL-2) and IL-3 signaling by accelerating SOCS3 degradation. Mol. Cell. Biol. 2005, 25, 9115–9126. [Google Scholar] [CrossRef]
- Piessevaux, J.; Lavens, D.; Montoye, T.; Wauman, J.; Catteeuw, D.; Vandekerckhove, J.; Belsham, D.; Peelman, F.; Tavernier, J. Functional cross-modulation between SOCS proteins can stimulate cytokine signaling. J. Biol. Chem. 2006, 281, 32953–32966. [Google Scholar] [CrossRef]
- Kausar, S.; Abbas, M.N.; Qian, C.; Zhu, B.; Sun, Y.; Sun, Y.; Wang, L.; Wei, G.; Maqsood, I.; Liu, C.L. Serpin-14 negatively regulates prophenoloxidase activation and expression of antimicrobial peptides in Chinese oak silkworm Antheraea pernyi. Dev. Comp. Immunol. 2017, 76, 45–55. [Google Scholar] [CrossRef]
- Schwarz, H.; Posselt, G.; Wurm, P.; Ulbing, M.; Duschl, A.; Horejs-Hoeck, J. TLR8 and NOD signaling synergistically induce the production of IL-1β and IL-23 in monocyte-derived DCs and enhance the expression of the feedback inhibitor SOCS2. Immunobiology 2013, 218, 533–542. [Google Scholar] [CrossRef]
- Hu, J.; Lou, D.; Carow, B.; Winerdal, M.E.; Rottenberg, M.; Wikström, A.C.; Norstedt, G.; Winqvist, O. LPS regulates SOCS2 transcription in a type I interferon dependent autocrine-paracrine loop. PLoS ONE 2012, 7, e30166. [Google Scholar] [CrossRef] [Green Version]
- Zhang, Y.; Zhao, J.; Zhang, H.; Gai, Y.; Wang, L.; Li, F.; Yang, J.; Qiu, L.; Song, L. The involvement of suppressors of cytokine signaling 2 (SOCS2) in immune defense responses of Chinese mitten crab Eriocheir sinensis. Dev. Comp. Immunol. 2010, 34, 42–48. [Google Scholar] [CrossRef]
- Sun, J.J.; Lan, J.F.; Xu, J.D.; Niu, G.J.; Wang, J.X. Suppressor of cytokine signaling 2 (SOCS2) negatively regulates the expression of antimicrobial peptides by affecting the Stat transcriptional activity in shrimp Marsupenaeus japonicus. Fish Shellfish Immunol. 2016, 56, 473–482. [Google Scholar] [CrossRef]
- Abbas, M.N.; Kausar, S.; Sun, Y.X.; Sun, Y.; Wang, L.; Qian, C.; Wei, G.Q.; Zhu, B.J.; Liu, C.L. Molecular cloning, expression, and characterization of E2F transcription factor 4 from Antheraea pernyi. Bull. Entomol. Res. 2017, 107, 839–846. [Google Scholar] [CrossRef]
- Abbas, M.N.; Kausar, S.; Sun, Y.X.; Tian, J.W.; Zhu, B.J.; Liu, C.L. Suppressor of cytokine signaling 6 can enhance epidermal growth factor receptor signaling pathway in Bombyx mori (Dazao). Dev. Comp. Immunol. 2018, 81, 187–192. [Google Scholar] [CrossRef]
- Kamizono, S.; Hanada, T.; Yasukawa, H.; Minoguchi, S.; Kato, R.; Minoguchi, M.; Hattori, K.; Hatakeyama, S.; Yada, M.; Morita, S.; et al. The SOCS box of SOCS-1 accelerates ubiquitin-dependent proteolysis of TEL-JAK2. J. Biol. Chem. 2001, 276, 12530–12538. [Google Scholar] [CrossRef]
- Babon, J.J.; Sabo, J.K.; Zhang, J.-G.; Nicola, N.A.; Norton, R.S. The SOCS box encodes a hierarchy of affinities for Cullin5: Implications for ubiquitin ligase formation and cytokine signalling suppression. J. Mol. Biol. 2009, 387, 162–174. [Google Scholar] [CrossRef]
- Dhawan, R.; Gupta, K.; Kajla, M.; Kumar, S.; Gakhar, S.K.; Kakani, P.; Choudhury, T.P.; Gupta, L. Molecular characterization of SOCS gene and its expression analysis on Plasmodium berghei infection in Anopheles culicifacies. Acta Trop. 2015, 152, 170–175. [Google Scholar] [CrossRef]
- De Zoysa, M.; Lee, J. Suppressor of cytokine signaling 2 (SOCS-2) homologue in disk abalone: Cloning, sequence characterization and expression analysis. Fish Shellfish Immunol. 2009, 26, 500–508. [Google Scholar] [CrossRef]
- Lee, Y.; Choi, J.-y.; Oh, C.; Kang, D.-H.; Choi, S.-y.; Heo, G.-J.; Lee, J.; De Zoysa, M. Molecular cloning and characterization of SOCS-2 from Manila clam Ruditapes philippinarum. Fish Shellfish Immunol. 2014, 36, 453–458. [Google Scholar] [CrossRef]
- Chakrabarti, S.; Dudzic, J.P. Remote Control of Intestinal Stem Cell Activity by Haemocytes in Drosophila. PLoS Genet. 2016, 12, e1006089. [Google Scholar] [CrossRef] [Green Version]
- Lad, S.P.; Fukuda, E.Y.; Li, J.; de la Maza, L.M.; Li, E. Up-regulation of the JAK/STAT1 signal pathway during Chlamydia trachomatis infection. J. Immunol. 2005, 174, 7186–7193. [Google Scholar] [CrossRef]
- Barillas-Mury, C.; Han, Y.S.; Seeley, D.; Kafatos, F.C. Anopheles gambiae Ag-STAT, a new insect member of the STAT family, is activated in response to bacterial infection. EMBO J. 1999, 18, 959–967. [Google Scholar] [CrossRef]
- Greenhalgh, C.J.; Hilton, D.J. Negative regulation of cytokine signaling. J. Leukoc. Biol. 2001, 70, 348–356. [Google Scholar]
- Abbas, M.N.; Zhu, B.J.; Kausar, S.; Dai, L.S.; Sun, Y.X.; Tian, J.W.; Liu, C.L. Suppressor of cytokine signaling 2-12 regulates antimicrobial peptides and ecdysteroid signaling pathways in Bombyx mori (Dazao). J. Insect. Physiol. 2017, 103, 47–56. [Google Scholar] [CrossRef]
- Kausar, S.; Liu, R.; Gul, I.; Abbas, M.N.; Cui, H. Transcriptome Sequencing Highlights the Regulatory Role of DNA Methylation in Immune-Related Genes’ Expression of Chinese Oak Silkworm, Antheraea pernyi. Insects 2022, 13, 296. [Google Scholar] [CrossRef]
- Hedengren-Olcott, M.; Olcott, M.C.; Mooney, D.T.; Ekengren, S.; Geller, B.L.; Taylor, B.J. Differential activation of the NF-kappaB-like factors Relish and Dif in Drosophila melanogaster by fungi and Gram-positive bacteria. J. Biol. Chem. 2004, 279, 21121–21127. [Google Scholar] [CrossRef]
- Lavine, M.D.; Strand, M.R. Haemocytes from Pseudoplusia includens express multiple alpha and beta integrin subunits. Insect. Mol. Biol. 2003, 12, 441–452. [Google Scholar] [CrossRef]
- Li, C.; Zhang, K.; Pan, G.; Zhang, L.; Hu, X.; Zhao, G.; Deng, C.; Tan, M.; Li, C.; Xu, M.; et al. Bmintegrin β1: A broadly expressed molecule modulates the innate immune response of Bombyx mori. Dev. Comp. Immunol. 2021, 114, 103869. [Google Scholar] [CrossRef]
- Zhang, K.; Su, J.; Hu, X.; Yan, X.; Chen, S.; Li, C.; Pan, G.; Chang, H.; Tian, W.; Abbas, M.N.; et al. Integrin β2 and β3: Two plasmatocyte markers deepen our understanding of the development of plasmatocytes in the silkworm Bombyx mori. Insect Sci. 2022, 1–13. [Google Scholar] [CrossRef]
- Li, C.S.; Kausar, S.; Gul, I.; Yao, X.X.; Li, M.Y.; Chen, C.C.; Abbas, M.N.; Dai, L.S. Heat shock protein 20 from Procambarus clarkii is involved in the innate immune responses against microbial infection. Dev. Comp. Immunol. 2020, 106, 103638. [Google Scholar] [CrossRef]
- Kausar, S.; Abbas, M.N.; Cui, H. A review on the DNA methyltransferase family of insects: Aspect and prospects. Int. J. Biol. Macromol. 2021, 186, 289–302. [Google Scholar] [CrossRef] [PubMed]
- Zhao, X.; Drlica, K. Reactive oxygen species and the bacterial response to lethal stress. Curr. Opin. Microbiol. 2014, 21, 1–6. [Google Scholar] [CrossRef] [PubMed]
- Dai, L.S.; Yu, X.M.; Abbas, M.N.; Li, C.S.; Chu, S.H.; Kausar, S.; Wang, T.T. Essential role of the peroxiredoxin 4 in Procambarus clarkii antioxidant defense and immune responses. Fish Shellfish Immunol. 2018, 75, 216–222. [Google Scholar] [CrossRef] [PubMed]
- Abbas, M.N.; Kausar, S.; Cui, H. The biological role of peroxiredoxins in innate immune responses of aquatic invertebrates. Fish Shellfish Immunol. 2019, 89, 91–97. [Google Scholar] [CrossRef]
- Letunic, I.; Bork, P. 20 years of the SMART protein domain annotation resource. Nucleic Acids Res. 2018, 46, D493–D496. [Google Scholar] [CrossRef]
- Chen, C.; Yang, L.; Abbas, M.N.; Zou, D.; Li, J.; Geng, X.; Zhang, H.; Sun, Y. Relish regulates innate immunity via mediating ATG5 activity in Antheraea pernyi. Dev. Comp. Immunol. 2022, 132, 104406. [Google Scholar] [CrossRef]
- Bacchetti De Gregoris, T.; Aldred, N.; Clare, A.S.; Burgess, J.G. Improvement of phylum- and class-specific primers for real-time PCR quantification of bacterial taxa. J. Microbiol. Methods 2011, 86, 351–356. [Google Scholar] [CrossRef]
- Grabherr, M.G.; Haas, B.J.; Yassour, M.; Levin, J.Z.; Thompson, D.A.; Amit, I.; Adiconis, X.; Fan, L.; Raychowdhury, R.; Zeng, Q.; et al. Full-length transcriptome assembly from RNA-Seq data without a reference genome. Nat. Biotechnol. 2011, 29, 644–652. [Google Scholar] [CrossRef] [Green Version]

Publisher’s Note: MDPI stays neutral with regard to jurisdictional claims in published maps and institutional affiliations. |
© 2022 by the authors. Licensee MDPI, Basel, Switzerland. This article is an open access article distributed under the terms and conditions of the Creative Commons Attribution (CC BY) license (https://creativecommons.org/licenses/by/4.0/).
Share and Cite
Kausar, S.; Gul, I.; Liu, R.; Ke, X.-X.; Dong, Z.; Abbas, M.N.; Cui, H. Antheraea pernyi Suppressor of Cytokine Signaling 2 Negatively Modulates the JAK/STAT Pathway to Attenuate Microbial Infection. Int. J. Mol. Sci. 2022, 23, 10389. https://doi.org/10.3390/ijms231810389
Kausar S, Gul I, Liu R, Ke X-X, Dong Z, Abbas MN, Cui H. Antheraea pernyi Suppressor of Cytokine Signaling 2 Negatively Modulates the JAK/STAT Pathway to Attenuate Microbial Infection. International Journal of Molecular Sciences. 2022; 23(18):10389. https://doi.org/10.3390/ijms231810389
Chicago/Turabian StyleKausar, Saima, Isma Gul, Ruochen Liu, Xiao-Xue Ke, Zhen Dong, Muhammad Nadeem Abbas, and Hongjuan Cui. 2022. "Antheraea pernyi Suppressor of Cytokine Signaling 2 Negatively Modulates the JAK/STAT Pathway to Attenuate Microbial Infection" International Journal of Molecular Sciences 23, no. 18: 10389. https://doi.org/10.3390/ijms231810389
APA StyleKausar, S., Gul, I., Liu, R., Ke, X.-X., Dong, Z., Abbas, M. N., & Cui, H. (2022). Antheraea pernyi Suppressor of Cytokine Signaling 2 Negatively Modulates the JAK/STAT Pathway to Attenuate Microbial Infection. International Journal of Molecular Sciences, 23(18), 10389. https://doi.org/10.3390/ijms231810389

